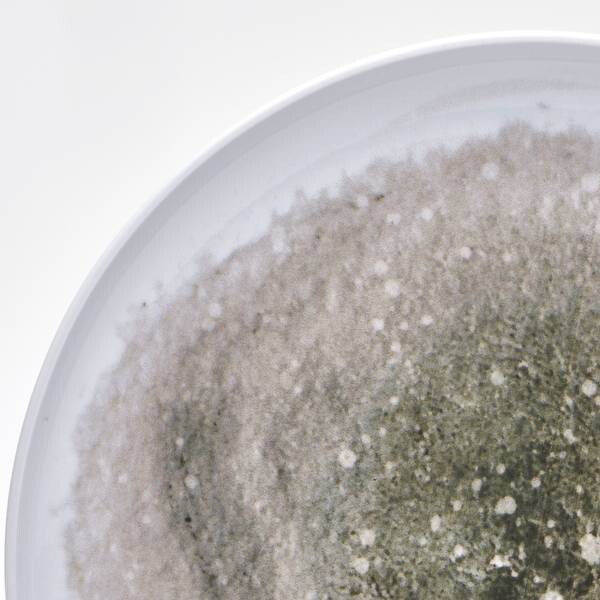

Комбинированный сервиз фару 16 шт. Van Well, зеленый
Описание
Бренд: Van WellЦвет: зеленыйМатериал: Фарфор Сборка не требуется Количество упаковок (всего): 1Количество штук в наборе: 16Комплект поставки: 4 кофейные кружки (по 2 каждого цвета) 40,0 мл: Идеально для наслаждения кофе или другими напитками. 4 десертные тарелки (по 2 каждого цвета) 20,4 см: Идеально подходят для небольших угощений и десертов. 4 глубокие тарелки (по 2 каждого цвета) 19,0 см: подходят для супов, тушеных блюд и салатов. 4 плоские обеденные тарелки (по 2 каждого цвета) диаметром 27,0 см: идеально подходят для основных блюд и закусок.Уход: Рекомендации по уходу: Можно мыть в посудомоечной машине Форма: Круглая
Характеристики
| Weight: | 8500 |
График изменения цены & курс обмена валют
Пользователи также просматривали

1,107.13 руб.
Muay Thai Shorts Satin Polyester Embroidery Boxing Shorts Men Women Child Martial Arts Combat Kickboxing Cage Fighting MMA Pants
aliexpress.com
865.00 руб.
Носилки для перчаток для гольфа Вешалка для перчаток Рама для поддержки перчаток Стойка Сушилка Инструмент для формовки Аксессуары для гольфистов чёрный
joom.ru
3,690.00 руб.
Накидки Автопилот для Лексус Н-Икс (2017 - 2021) / Lexus NX на передние сиденья, Бежевый
goods.ru
740.00 руб.
Рыболовная сеть с телескопическим полюсом, искусственное рыболовное снаряжение, сеть для наживки, Забавная детская игрушка для рыбалки, Пляжная игрушка для улицы
aliexpress.ru
304.03 руб.
Handlebar Helmets Rack Replaceable Motorcycle Hanger Heavy Duty Aluminum Alloy Handlebar Hanger For Scooter Electric Bike
aliexpress.com
149.97 руб.
1 Set Dust Plugs Cover for Switch\Switch Game Console Replacement Protectors W3JD
aliexpress.com
2,477.33 руб.
2023 New Men's Quartz Wristwatches Luxury Gold Stainless Steel Waterproof Luminous Dual Calendar Business Watch Male Clock Gifts
aliexpress.com
1,693.07 руб.
Fast Qi Wireless Charger Stand for Samsung Active Charging Dock for Watch 4 3
aliexpress.com
1,505.41 руб.
3X For Bmw R1200gs Adv F800gs F700gs Crf1000l Africa Twin Crf1000 Motorcycle Beverage Water Bottle Drink Cup Holder
aliexpress.com
1,205.47 руб.
Chainsaw Parts Carburetor Replacement Parts for Stihl TS410 TS420 TS 420 Fuel Cut-Off Machine
aliexpress.com
3,473.01 руб.
PVC Heat Shrink Cylinder Film Shrink Packaging Transparent Film Can Be Cut for Home Hair Dryer Hot Air Plastic Sealing Film
aliexpress.com
4,180.23 руб.
Outdoor Lamp Garden Spike Path Spotlights Decoration Garden Waterproof Led Light Lighting Lawn
aliexpress.com
11,472.89 руб.
Original 14'' laptop assembly with cover FHD for ASUS ZenBook 14 Lingya Deluxe14 UX433FN UX433FA UX433 LCD screen assembly
aliexpress.com
2,532.23 руб.
Мягкие плюшевые наушники, Зимние теплые наушники для женщин и мужчин, уличные защитные наушники, модные однотонные наушники для взрослых
aliexpress.ru703.88 руб.
Diskont Jdm Project - 20 Stiker Mapel - Label Buku Pelajaran Sekolah - Stiker Mata Pelajaran
shopee.co.id
681.00 руб.
W1088 Dual Digital Temperature Controller Temperature Sensor Incubator Thermostat Direct Output Heating Cooling Control Switch
aliexpress.com
22,125.47 руб.
8MP HD Outdoor Dome Weatherproof TVI Cameras Home 4K Video Security Cameras Kit Day Night Vision CCTV Surveillance Smart IR Kit
aliexpress.com
3,900.78 руб.
FGHGF NEW Women's Pumps Shoes Sexy Women's Nude Lace-Up Shoes With Nude Feet And 16CM Stilettos
aliexpress.com
6,193.72 руб.
BIKINGBOY Legent 900 TT 98 99 00 01 Adventurer 900 885 96-01 97 for Thunderbird 885 95-13 12 11 10 Front Brake Disc Rotor Disk
aliexpress.com
516.28 руб.
3525 Control Small Plate Welding Machine Drive Small Plate Belt 4688 Drive Board 200 250 Welding Control Board
aliexpress.com
4,987.43 руб.
Leather Jacket Women Pu Faux Leather Jackets Short Coat Black Pockets Zippers Embroidery Motorcycle Biker Autumn Winter Coats
aliexpress.com
625.27 руб.
The Warriors Vintage Classic Movie Poster Home Decor Wall Decor Wall Art Canvas painting Cnavas print
aliexpress.com
23,601.38 руб.
Gold Ball Gown Evening Dresses Long Sexy Straps Crystals Tulle Evening Gown Formal Dress YQLNNE
aliexpress.com
1,858.61 руб.
Ksperway 8" Set of 2 Unscented Real Wax Moving Wick Flameless Taper Candles with 5 Hours On/19 Hours Off Timer Fuction Black
aliexpress.com
343.37 руб.
SUNON orginal PMD1204PQBX-A 4CM 4028 12V 6.8W high- speed server fans 40*40*28mm
aliexpress.com
417.12 руб.
100% Original Battery HB554666RAW 1780mAh For Huawei 4G Lte WIFI Router E5372 E5373 E5375 EC5377 E5330 Replacement Phone battery
aliexpress.com
68.84 руб.
Knot Cross Tie Solid 1 PC Fashion Hair Band Headband Knitted Rib Girls Bow Hoop Hair Accessories Velvet Twist Headband #O
aliexpress.com
2,761.69 руб.
diy electronic starter kit set for Arduino start with uno r3 board RFID RC522 lcd1602 830 breadboard
aliexpress.com
81.95 руб.
1/2/5/10 Pcs Ultra Thin Clear HD LCD Screen Guard Protector Film With Cleaning Cloth Film For Smartisan Nut 3.
aliexpress.com
8,319.48 руб.
Elegant White Boho Wedding Dresses A Line Chiffon Bohemian Beach Country Garden Bride Bridal Gowns Plus Size Custom Made
aliexpress.com
118.83 руб.
MEIBEADS 10pcs/lot DIY Handmade Sweater With Scarf Brooch Pin Buckle Simple Large Jewelry Materials Accessories UF7367
aliexpress.com
117.19 руб.
Women‘’s Winter Warm Gloves Fashion Touch Screen Gloves Solid Color Full Finger Leather Gloves For Driving Ski #LR25
aliexpress.com58.18 руб.
For Huawei Honor 10 9 8 7 Lite Case Silicone Cute pattern painting Soft Cover For Huawei 8X MAX 7S 7X 7A 7C Pro Phone Case
aliexpress.com
1,532.45 руб.
2019 Disney 40-130CM Mickey Minnie Cartoon Plush Toy Stuffed Toy Doll Cute Cartoon Animal Birthday Gifts For Kids Baby Children
aliexpress.com
508.09 руб.
3-in-one data line mobile phone cable mobile phone charger mobile phone flexible cable power cable USB, 120 mm long
aliexpress.com